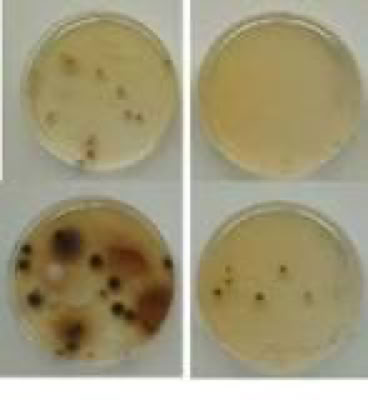

Akt.: 138.26
Kolloidales Silber
Info zu kolloidalem Silber in unseren Produkten:
In verschiedenen unserer Reiniger, sowie im Silverline oder Fleckschutz befindet sich kolloidales Silber. Natürlich möchten wir dadurch nicht in die Nanotechnologie, Feinstaubpartikel oder Feinstaubverordnung gehen, daher ist die Menge begrenzt
(unter 0.01% Volumen). Trotzdem können auf Grund mehrerer Versuchsreihen auf ein sehr positives Ergebnis zurückgreifen. Klar ausgesagt war es erst mal als Werbeeffekt gedacht. Trotz all dem hat der Einsatz enorme Wirkung gezeigt. Desinfektionsreiniger etc. können wir durch den Einsatz natürlich nicht ersetzten. Die Wirkung ist auf Grund der Menge zu gering. In den Produkten wie unserem Silverline befindet sich natürlich mehr Menge, welche jedoch noch nicht in die Biozidverordnung fällt. Durch das einbinden im Fleckschutz werden keine Partikel frei, daher entsteht auch keine Feinstaubbelastung.
Da unser Naturgedanke Konservierungsmittel zu sparen, gereinigtes Wasser zu verwenden und mit kolloidalem Silber zu arbeiten
ermöglicht uns den nächsten Schritt in der Naturausrrichtung zu gehen. Bitte haben Sie Verständnis, wenn wir die Einsatzmengen
daher nicht erhöhen, um jeglicher Problematik bezüglich Feinbelastung aus dem Wege zu gehen. Die Geschäftsleitung!
Das kolloidale Silber entsteht durch einen Prozess, den man Elektrolyse nennt. Unser Material entsteht in 2fach selbst destilliertem Wasser. Kolloidales Silber ist eine beliebte Alternative im Gesundheitswesen wie z.B. für Antibiotika, keimtötend etc.. Nicht ganz zu unrecht. Denn seine antibakterielle Wirkung ist unbestritten. Mehr noch, es wirkt gegen Viren. Das können Antibiotika definitiv nicht. Und es hat nicht die gefährlichen Nebenwirkungen der zellschädigenden resistenzbildenden Bakterienkiller wirken extrem effektiv. Bedenkenlos sollten die superfeinen Silberionen dennoch nicht eingesetzt werden. Wir haben unser Verfahren entwickelt um möglichst unser Anliegen damit abzudecken. Nämlich Reinigungs- und Behandlungsmittel zusätzlich aktivieren zu können. Kolloidales Silber ist ein Antibiotikum mit der Fähigkeit Pilze, Viren, Bakterien und Parasiten zu eliminieren. Es wirkt Antibakteriell. Es handelt sich dabei um ein besonderes Mineral, das Mikroorganismen und andere Krankheitserreger effektiv abtötet. Unter anderem deshalb ist kolloidales Silber so wirksam.
Hält man sich die positiven Eigenschaften von kolloidalem Silber vor Augen, dann denkt man, ein Wundermittel in den Händen zu halten. Kolloidales Silber wirkt gegen Bakterien, Pilze und sogar Viren. Da es auf Oberflächen keine Gehrung zulässt, so wirkt es auch geruchshemmend. Es verursacht keine Resistenzbildung und hat im Gegensatz zu Flächendesinfektionsmitteln keine schädlichen Auswirkungen auf Menschen. Oberflächenfaulbakterien bei Fliesen, Stein, Holz Kork oder saugende Materialien wie Fugenmassen aus Zement haben keine Chance. Die Wirkung von kolloidalem Silber beruht auf Tatsachen und überliefertem Wissen.
Wie sich kolloidales Silber bei oraler Einnahme oder Dauereinnahme benimmt, möchten wir hier nicht Kund geben und teilen auch nicht unbedingt alles was landläufig berichtet wird. Es hat sich aber für uns als wunderbar verwertbar mit erstklassigen Eigenschaften bewährt. Klare Tatsachen auf der Haut und Einnahme sind zwar bekannt, wir setzten es jedoch für unsere Zwecke höchst erfolgreich ein und können tatsächlich über unglaubliche Ergebnisse berichten.
Nicht ohne Grund, wurde früher aus Silberkrügen getrunken oder Silberlinge in Milch zur Haltbarkeitsverlängerung gelegt, Silberbesteck benutzt oder Obst auf Silberplatten serviert. Welch phänomenales Wissen wir uns heute zu Nutzen machen können, ist unfassbar. Wir haben verstanden und stellen kolloidales Silber in einem eigens eingerichteten Reinraum her, so das wir es sogar Apotheken anbieten dürften.
Weniger ist mehr.
Wir könnten auf Grund der Eigenproduktion den Silbergehalt unermesslich hoch einbringen, was aber nicht zielführend wäre. Unserem naturreinen Reinigungssystem verabreichen wir gezielte Mengen von kolloidales Silber und auch zum Teil Grapefruitkernextrakt. Was sollen wir sagen, es ist grandios mit solchen Naturstoffen zu arbeiten.
Silverline Fugenschutz PREMIUM:
Unser neuer Silverline Fugenschutz PREMIUM wurde geradezu perfekt abgestimmt, zwischen Schutzbehandlung und abweisend von Bakterien, Schimmel etc. Hier bringen wir in und auf das Fugenmaterial genau die richtige Menge Silberionen. Selbst eingestrichene Silikonfugen halten länger schimmelfrei.
Unsere Reiniger:
Was für eine Errungenschaft unsere Idee war zeigt sich bei vielen zufriedenen Kunden.
Bild von Wikipedia: Keimschalen zeigen die enorme Wirkung beider Stoffe
Keimschalen
Herstellung des KS bei uns: Reinwasser TYP 1* gereinigt auf 0,1 – 0,4 mikrosiemens und energetisiert in 15 Stufen. Edelmetall Reinheitsstufe 99,99 % (96% ionisch, 4% kolloidal) auf 50 PPM konzentriert. *Reinstwasser TYP 1 ist das reinste auf dem Markt erhältliche Wasser, das strengsten Kriterien der Leitfähigkeit, des organischen Kohlenstoffgehalts [TOC] und der bakteriologischen Qualität genügt. Es wird die Anwendung in Laboren, wie in der Molekularbiologie, verwendet. Wir verwenden zweifach destilliertes Wasser.
Eigenschaften des Produkts: Pures Silber 99,99%, Ohne weitere Zusätze – enthält kein Silberchlorid, keine Proteine und keine Salze, Konzentration von 50 PPM (50 mg pro Liter), Reinste Silber-Dispersionen. Optimaler Anteil an positiv geladenen Ionen. Mit zweifach destilliertem Reinstwasser hergestellt (Typ1 gereinigt auf 0,1-0,4 mikrosiemens und energetisiert in 15 Stufen)
Optimale Verteilung der Partikel, Abgefüllt in phthalatfreier, lichtgeschützter Umgebung. Das kolloidale Silber eignet sich folglich für den Einsatz verschiedenster Werkstoffe.
Da nun unsere gesamten Premium Fleckschutzprodukte und Alltagsreiniger mit gereinigtem Wasser hergestellt werden, sind wir in der Lage, unter langer Einarbeitung über 35Grad das Kolloidale Silber unseren Produkten beizusetzen, welche anschließend eine Antibakterielle Wirkung zeigen. Ein drei Jahrestest hat ergeben, das die Wirkung erst nach 3 Jahren Lagerung unserer Produkte schwächer wird, jedoch noch immer ausreichend wirkt.
Das Zahlungssystem:
Grund unserer Affinität zu Silber akzeptieren wir es auch als Zahlungsmittel.
Unser Einsatz von Grapefruitkernextrakt:
Wie auch Silberionen hat Grapefruitkernextrakt eine antiseptische Wirkung. Beides wird in unseren Reinigern verwendet. Seit 2018 auch in den Sanitärproduken, Schimmelentferner, alles Reinigern.
Grapefruit: